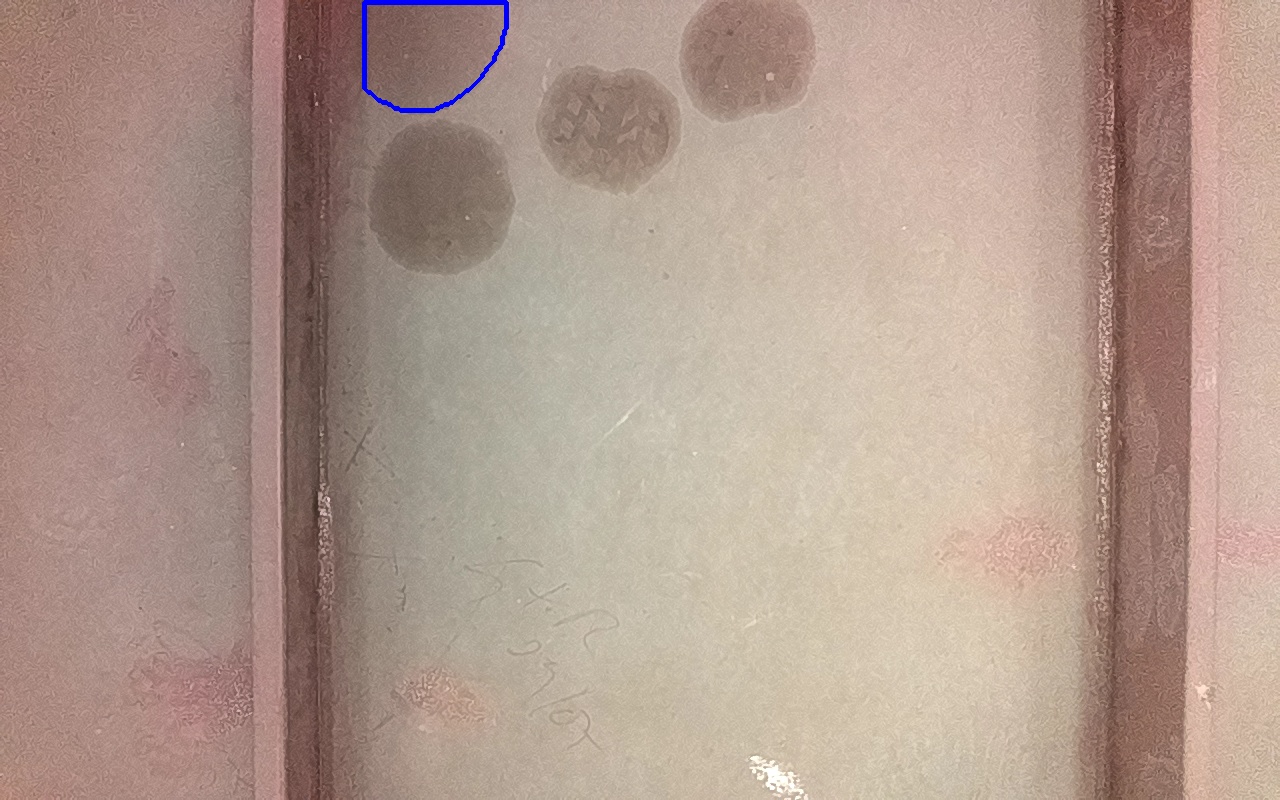

Discontinuidad detectada
| Tipo |
IV-2
Marcas de aceite o grasa. Suciedades o todo tipo de contaminantes solubles. |
|---|---|
| Fecha | 25/06/2025 12:53 |
| Tamaño (mm) | 8257 mm2 |
| Tamaño (m) | 0.0083 m2 |
| Confianza | 56.25 % |
| Posición |
X: 2.87 Y: 0.02 Z: 0.02 |
| Resultado |